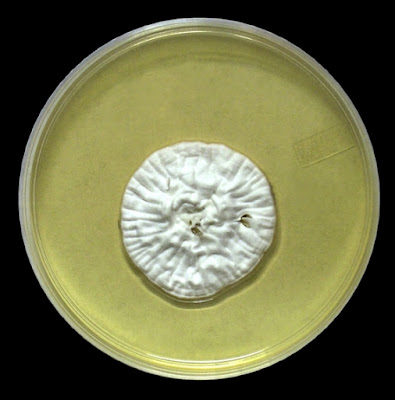

Emmonsia pasteuriana
Note: I've held back on uploading this particular post only because I'm not satisfied with the quality of the photographs I've taken. It is unlikely that I will come across another strain of this fungus in my career so I will post it at this time hoping any readers will understand.
Emmonsia species: Emmonsia currently consists of three species: E.parva, E.crescens &E.pasteuriana.
Ecology: Emmonsia is a cosmopolitan soil saprobe (found just about in all temperate climates and lives of decaying organic matter). It has been isolated from a variety of mammalian species, particularly small rodents.
Pathogenicity: Emmonsia parva and Emmonsia crescens are the etiologic agents of adiaspiromycosis. Usually this presents as an asymptomatic pulmonary infection in animals, and more recently in immunocompromised humans after the inhalation of the fungal spores. Lung biopsy may be necessary to diagnose the illness as the organisms may not be present in sputa or bronchial alveolar lavages. Dissemination of the infection may occur more readily in immunocompromised hosts. E.crescens is more commonly isolated from humans while E.parva is isolated more often from animals.
Reports of E.pasteurianahave increased in recent years, presenting as disseminated cutaneous (skin) mycosis in persons with underlying AIDS infections[i]. Unlike E.parvaand E.crescens, E.pasteuriana does not produce adiaconidia and therefore does not cause adiaspiromycosis. E. pasteurianaappears as yeast in infected tissue.
Emmonsia pasteuriana:
Macroscopic Morphology: E.pasteuriana exhibits slow to moderate growth at 30ᵒC, with a colony diameter of about 25mm after 10 days and 60mm after 21 days. The colony appeared velvety to powdery in texture with folded, wrinkled, or cerebriform surface contours. The colony spontaneously acquired splits in the surface as it aged (see photo) The colony was primarily white in colour and remained so while some sources state that it may develop a light brown colour as it ages. The colony produced no diffusible pigment. The reverse was tan or light brown in colour.
Emmonsia pasteuriana - Saboraud-Dextrose Agar. The splits in the colony were created by the growth and not by any prodding of my own. (SAB), 30ᵒC, 1 Month. (Nikon)
Emmonsia pasteuriana - Dermasel® agar, 30ᵒC, ~18 Days. (Nikon)
Microscopic Morphology: Emmonsia pasteuriana is a dimorphic fungus meaning it can exhibit the filamentous fungus form at one temperature and the yeast form at another.
Filamentous form:This isolate produce septate, hyaline (non-pigmented) hyphae of about 1.0 to 1.3 µm diameter. Thin-walled, slightly verruculose (minutely verrucose or warty), globose to sub-globose (round-ish) conidia (2 – 3 µm X 3 – 4 µm) are formed on slender (0.4 – 0.5 µm) pedicles (stalks) or at the apex of inflated cells. Initially a conidium may be found at the end of a delicate pedicle which may then develop further to form four to eight pedicles with conidia, establishing a ‘floret’. Additional sessile or broad-based verrucose (warty) conidia may also be present.
Emmonsia pasteuriana - hyphae with conidia visible throughout.
(400X, LPCB, DMD-108)
Emmonsia pasteuriana - Globose to sub-globose (round-ish) conidia. They are generally found at the end of a delicate pedicile (stem) which can barely be seen at this magnification. A few more photos to follow of much the same as this is this really was my first impression of this fungus and what clued me into what it might be.
(400X, LPCB, Nikon)
Emmonsia pasteuriana - ditto. Numerous conidia formed.
(400X, LPCB, Nikon)
Emmonsia pasteuriana - another as previously, but here in this photo there may be evidence of the conidia occuring in small bunches, each on its own pedicile branching off from a central delicate pedicile. (400X, LPCB, Nikon)
Emmonsia pasteuriana -small conidia occuring in bunches (as previously)
(400X, LPCB, Nikon)
Emmonsia pasteuriana - and another.
(400X, LPCB, Nikon)
Emmonsia pasteuriana -at a higher magnification, the rather round (globose) or 'round-ish' (sub-globose) conidia can be seen with a couple at the end of a pedicile (stem or stalk) and one (center-left) which may be growing directly from the hypha (sessile).
(1000X, LPCB, DMD-108)
Emmonsia pasteuriana -small clusters of conidia.
(1000X, LPCB, DMD-108)
Emmonsia pasteuriana - as above. It was my impression of the tiny, round conidia attached by a delicate pedicile which directed me to the identity.
(1000X, LPCB, DMD-108)
Emmonsia pasteuriana - a solitary conidium at the end of a pedicile is seen in this photo (inset)
(1000X, LPCB, DMD-108)
Emmonsia pasteuriana - Initially a conidium may be found at the end of a delicate pedicle (see above) which may then develop further to form four to eight pedicles with conidia, establishing a ‘floret’. Here we see more distinctly what is described as a 'floret' (inset).
(400+10X, LPCB, DMD-108)
Emmonsia pasteuriana -a very good example of the 'floret', usually composed of between 4 to 8 conidia at the end of the slender delicate and slender (0.4 – 0.5 µm) pedicles.
(1000X, LPCB, Nikon)
Emmonsia pasteuriana -another example of a 'floret' as above.
(1000X, LPCB, DMD-108)
Emmonsia pasteuriana -a string of florets along a delicate hyaline (non-pigmented) hypha of about of about 1.0 to 1.3 µm diameter running through the photo from lower left to upper right.
(1000X, LPCB, Nikon)
Emmonsia pasteuriana -a string of florets along delicate hyaline (non-pigmented) hyphae.
(400X, LPCB, Nikon)
Emmonsia pasteuriana - Additional sessile (directly from hypha) or broad-based verrucose (warty) conidia may also be produced.
(1000X. LPCB, Nikon)
Emmonsia pasteuriana - once again, single conida on slender stalks.
(400X, LPCB, DMD-108)
Emmonsia pasteuriana - two conidia can be seen at center left, attached to the delicate pedicile.
(400+10X, LPCB, DMD-108)
Emmonsia pasteuriana -sessile (directly from hypha) or broad-based verrucose (warty) conidia may be produced. (1000X, LPCB, DMD-108)
Emmonsia pasteuriana - Once again, thin-walled, slightly verruculose (minutely verrucose or warty), globose to sub-globose (round-ish) conidia (2 – 3 µm X 3 – 4 µm) are formed on slender (0.4 – 0.5 µm) pedicles (stalks) or at the apex of inflated cells. Here in this photo is a conidium at the apex of an inflated cell. (1000+10X, LPCB, DMD-108)
Emmonsia pasteuriana - more conidia at the born on delicate pediciles.
(1000X, LPCB, DMD-108)
Yeast form: The filamentous fungus form can be converted to the yeast form by incubating a freshly inoculated culture at 37ᵒC for 10 to 14 days. Conversion is enhanced by cultivation on the nutritionally richer Brain-Heat Infusion (BHI) agar. Smooth, butyrous colonies appear cream to beige in colour which may darken as they age. Colonies consist of globose to oval yeast colonies which may show narrow-based budding.
Emmonsia pasteuriana - isolate was inoculated onto Brain-Heart Infusion (BHI) agar and incubated at 37ᵒC for 14 days. Emmonsia pasteuriana converted to the yeast form which is the form that is directly recovered from skin lesions.
(400X, LPCB, DMD-108)
Emmonsia pasteuriana - a more convincing example of the yeast-like phase of E.pasteuriana.
(400+10X, LPCB, DMD-108)
Note: At various stages of development, Emmonsia species may resemble other fungi such as Blastomyces dermatitidis, Paracoccidioides brasiliensis, Histoplasma capsulatum and Chrysosporium species. It has been noted that some cross-reaction (false positives) may occur between Emmonsiaspecies and Blastomyces dermatitidiswith a both a DNA probe and direct immunofluorescent-antigen tests.
Adioconidia:When the hyphae and conidia are incubated at their maximum temperatures on enriched media, the hyphae become distorted and usually disintegrate while the conidia swell to become round, thick-walled adiaconidia (formerly called adiaospores). Production of adiaconidia is best achieved by incubation at increased temperatures: 37ᵒC for E.crescens (20 – 14 µm dia) and at 40ᵒC for E.parva (10 -25 µm dia). As previously mentioned, E.pasteurianacannotbe induced to produce adiaconidia at any temperature.
Physiology: Emmonsia pasteuriana is not inhibited by cycloheximide and therefore can be grown on Mycosel® or Dermasel® agar.
[i] A Dimorphic Fungus Causing Disseminated Infection in South Africa
Chris Kenyon M.D. et al.,
N.Engl. J. Med. 2013, 369 – 1416 - 1424